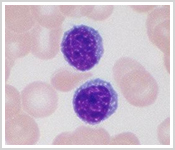
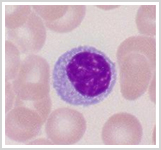

| 导入 |
|
各位学员,您好!
首先,问各位学员一个问题,你是什么血型?
有的是A型血,有的是B型血,有的是AB型血,有的是O型血。
再问你一个问题,如果已经知道父母的血型,能不能推测出儿女可能的血型?
看来,血型与遗传关系非常密切。
可是你一定会问,血型与细胞识别、免疫反应又有什么关系呢?
其实,血型与细胞识别、免疫反应的关系非常密切。
让我们先了解一下,人类ABO血型的分子基础,你就会明白其中的道理。
如果把不同血型的两个人的血,滴放在玻璃片上混合,在显微镜下观察,其中的红细胞会凝集,这种现象,我们称之为红细胞凝集。如图所示。

红细胞凝集的本质,就是抗原――抗体反应。
在凝集反应中,红细胞膜上的特异性抗原,我们称之为凝集原。
溶解在血浆中γ-球蛋白,能与红细胞膜上的凝集原发生反应,我们称之为凝集素。实际上,凝集素就是与红细胞膜上的特异性抗原,发生反应的特异性抗体。所以,不同血型的血液混合时,就发生了抗原--抗体反应,使红细胞凝集。
我们知道,当病人输入血型不相容的血液时,在血管内可发生抗原--抗体反应,使红细胞凝集,可以堵塞毛细血管,危及生命。
如果你对ABO血型感兴趣的话,不妨仔细研究一下广角镜1人类ABO血型的分子基础。
|
| 一、细胞膜外表面的糖类 |
|
细胞膜的糖类只分布在细胞的外表面,这些糖类被称为低聚糖,一般由1-10个单糖或者单糖衍生物组成。单糖或者单糖衍生物主要有半乳糖、甘露糖、岩藻糖、半乳糖胺、葡萄糖、葡萄糖胺和唾液酸等。

如图所示,单糖或者单糖衍生物组成的低聚糖,以共价键的形式连接在膜脂或膜蛋白分子上,形成糖脂和糖蛋白。糖脂和糖蛋白的低聚糖糖链分布在细胞膜的外表面。
一个糖脂分子上一般只连接一条低聚糖链,一个糖蛋白分子上常常结合着多条低聚糖糖链。因为,组成低聚糖糖链的单糖数量不同,单糖的种类不同,单糖之间的结合方式不同,单糖的排列顺序不同,组成的糖链有没有分支等,所以,糖链的结构十分复杂,而且,连接在膜蛋白和膜脂上的糖链,都在细胞膜的外表面。因此,糖链在细胞识别、物质交换、接触抑制等生理功能中发挥重要的作用。
动物体的细胞识别过程是高中生命科学第二册第五章第4节的重要内容,下面就让我们进一步来理解有关细胞识别的相关内容。

细胞识别由细胞膜外表面的糖链负责的,糖链组成千差万别。如图所示,糖链就像细胞表面上的接收天线、或者人类的指纹一样,可以识别或者被识别。而且细胞识别还具有细胞和组织的特异性,也就是细胞可以识别与自身性质相同或相似的细胞。
细胞识别或者被识别,在细胞生命活动中是常常发生的事情。其中,糖链上的唾液酸对识别起着非常重要的作用。
 
如图所示,血液中的巨噬细胞,它可以吞噬非机体自身的细胞(如细菌),或者衰老的细胞。当红细胞衰老后,细胞膜表面的糖链末端就会失去唾液酸,并且暴露出半乳糖残基,这时,衰老的红细胞就会被巨噬细胞表面的受体识别,并被吞噬。正常红细胞表面都有唾液酸遮蔽而得到保护。
要知道,巨噬细胞表面的受体是糖蛋白,它能识别衰老的红细胞,也是依靠巨噬细胞表面受体的糖链。细胞完成识别时,细胞膜表面的受体与外界信号分子,发生选择性的相互作用,从而导致细胞内一系列生理生化变化,通过一系列过程,把细胞外的信号转换为细胞内的信号,还可能会引起某些特定基因的表达。
|
| 三、免疫系统 |
|
既然对于动物来说,细胞识别过程是非常重要的生理过程,那么,动物体是否存在一个完整的系统,来保护机体免受外界干扰和侵袭呢?
这个系统已经被人们所认识,那就是免疫系统。
免疫系统由免疫器官、免疫细胞和免疫分子组成。
1.免疫器官

免疫器官又分为中枢免疫器官和外周淋巴器官。如图所示。
(1)中枢免疫器官
包括骨髓和胸腺。骨髓是各种免疫细胞的发源地。胸腺是T细胞分化发育的场所。
(2)外周淋巴器官
包括淋巴结、脾、扁桃体和粘膜淋巴组织,是成熟淋巴细胞定居的场所,也是生物体对外来抗原产生免疫应答的部位。
2.免疫细胞
免疫细胞是免疫系统的重要组成部分。免疫细胞是指参加免疫应答,或者与免疫应答有关的所有成熟细胞和前体细胞。

如图所示,造血干细胞经增殖、分化,生成各种成熟的血细胞,其中,白细胞参与机体的免疫反应,这些白细胞就是免疫细胞。因此,免疫细胞包括中性粒细胞、嗜酸性粒细胞、嗜碱性粒细胞、单核细胞、淋巴细胞等多种类型。其中,淋巴细胞又分成T细胞、B细胞、NK细胞等类型,T细胞和B细胞,在细胞免疫和体液免疫过程中,起重要作用。
我们知道,非特异性免疫是生命体在长期进化中遗传下来的,它们组成了抵御病原微生物的第一道防线。特异性免疫是生命体在个体发育过程中,与外界物质接触后产生的。
当病原微生物突破了第一道防线,特异性免疫系统中的T细胞和B细胞,组成了第二道防线。非特异和特异免疫系统,在抵御病原微生物的过程中,协同作用,相互补充、相互加强,建立了一道抵御病原微生物的强大的生理防线。
|
| 四、细胞免疫 |
|
机体的特异性免疫包括细胞免疫和体液免疫。
细胞免疫是通过免疫细胞发挥效应来清除异物。细胞免疫可分为,非特异性细胞免疫和特异性细胞免疫。
1.非特异性细胞免疫
 
非特异性细胞免疫,包括巨噬细胞对抗原物质的吞噬和破坏,NK细胞对靶细胞的杀伤作用等等。这些巨噬细胞、NK细胞的表面没有特异的识别受体,因此称之为非特异性细胞免疫。如图所示,人的NK细胞,巨噬细胞吞噬细菌。
2.特异性细胞免疫
特异性细胞免疫是一个由多细胞系参与完成的免疫应答过程。包括抗原的识别,T细胞的活化、增殖、分化,产生效应细胞等一系列过程。
T淋巴细胞是胸腺依赖性淋巴细胞的简称,来源于骨髓淋巴干细胞。
祖T细胞是在骨髓生成的,必须进入胸腺,才能发育为成熟T细胞,随后到达外周免疫器官。
T细胞是血液中主要的淋巴细胞,执行特异性细胞免疫应答,并参与体液免疫应答。

如图所示,T淋巴细胞的扫描电子显微镜照片。
机体的特异性体液免疫应答是由B淋巴细胞介导的。
1.B淋巴细胞的形成
在哺乳动物的骨髓中,淋巴干细胞经过分化,生成成熟的B淋巴细胞。
如图所示,未活化的B淋巴细胞。左侧为未活化的B淋巴细胞的光镜照片,右侧为未活化的B淋巴细胞的电镜照片。
|
| 五、体液免疫 |
|
2.浆细胞的产生
在抗原物质的诱导下,B淋巴细胞经过活化、增殖,最终分化为浆细胞,浆细胞合成并分泌特异性的抗体。
B淋巴细胞受抗原刺激后,形成的浆细胞,是体内惟一能产生抗体的免疫细胞。
如图所示,左侧为成熟的B淋巴细胞的光镜照片,右侧为浆细胞的电镜照片。
3.体液免疫应答
在生物体中,含千百万种不同的B淋巴细胞克隆,每一个B淋巴细胞克隆,都可以产生一种能与相应抗原特异结合的免疫球蛋白分子,免疫球蛋白分子被称为抗体。
这些B淋巴细胞在抗原刺激下,经过活化、增殖,分化为浆细胞,产生特异性抗体,参与体液免疫应答。

体液免疫应答有两个过程。如图所示。
(1)初次应答
抗原第一次进入机体,刺激机体产生免疫应答。初次应答潜伏期长,抗体效价低,抗体维持时间短。
机体经过初次应答后,产生了特异性记忆细胞。
(2)再次应答
当同种抗原再次进入机体,引起机体产生免疫应答。
再次应答的潜伏期缩短,抗体的浓度迅速升高,抗体持续时间长、效价高、亲和力强。
因为,机体经过初次应答后,产生了特异性记忆细胞。记忆细胞在体内生存时间较长,再次应答的能力可持续数月或数年。
|
